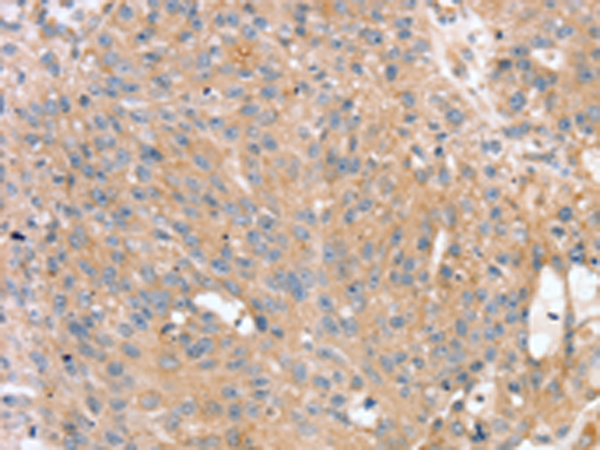

-
分类: 科研抗体货号: P05428别名: OX40; ACT35; CD134; IMD16; TXGP1L应用: WB反应种属: Human
-
分类: 科研抗体货号: P05388别名: AZU-1; ECTACC应用: WB,IHC反应种属: Human, Mouse
-
分类: 科研抗体货号: P05397别名: DGS; TGA; VCF; CAFS; CTHM; DGCR; DORV; VCFS; TBX1C; CATCH22应用: WB,IHC反应种属: Human
-
分类: 科研抗体货号: P05427别名: p33; TNFC; TNFSF3应用: IHC反应种属: Human, Mouse
-
分类: 科研抗体货号: P05382别名: STX3A应用: WB,IHC反应种属: Human, Mouse, Rat
-
分类: 科研抗体货号: P05396别名: MgcRabGAP应用: WB反应种属: Human
-
分类: 科研抗体货号: P05380别名: SDCN; SYND3应用: WB,IHC反应种属: Human, Mouse, Rat
-
分类: 科研抗体货号: P05426别名: TSG-14; TNFAIP5应用: WB,IHC反应种属: Human, Mouse
-
分类: 科研抗体货号: P05454别名: GON-2; MLSN2; LTRPC3应用: IHC反应种属: Human
-
分类: 科研抗体货号: P05424别名:应用: WB,IHC反应种属: Human, Mouse

鄂公网安备42018502007531号
鄂公网安备42018502007531号

